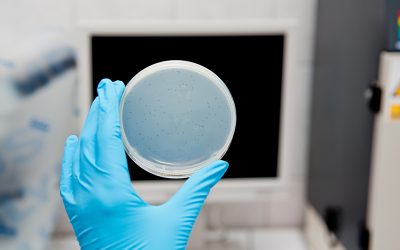
Are coliphages pathogenic?

BLOG
What are the water sample collection points, frequency, and indicator organisms that ensure that the water supplied to citizens is free of pathogens?
Microbiological analysis of drinking water emphasizes evaluating the hygienic quality of the supply. This requires isolation and enumeration of indicator organisms for the presence of fecal contamination.
A holistic approach to water management is becoming essential
Bluephage aims to become a key player in the mechanisms that assist difficult water resource management decisions by providing a faster, more accurate, and user-friendly technology for analyzing faecal and viral contamination in water.
Five main reasons justify the effectiveness of working with coliphages in the laboratory for regular microbiological water testing
BLOG | BluephageThese are key reasons for testing for coliphages in microbiological water analysis...
How pathogens in manure cause human disease
Fecal pollution sources from human or animal are among the most important loss of water quality.
Greater social awareness is needed to invest in innovative and sustainable technologies to treat human-generated waste, including water.
Bluephage promotes the sustainability of the water cycle by ensuring the microbiological safety of wastewater.
WHO warns on AMR to be one of the top 10 threats to global public health
Bluephage’s technology solutions can help prevent waterborne diseases.
Bluephage successfully closes its crowdfunding round beating its initial goal by 114% and raising €916,714 in just one month.
The entire Bluephage team would like to thank all of the more than 602 investors who believe in the Rapid Kit test for the analysis of coliphages,
What are the main sources of faecal contamination of water and how to control them in a water safety plan?
Bluephage’s team of experts offers consulting services to implement Water Safety Plans and monitor faecal water contamination through its Easy Kit and Rapid Kit, streamlining and drastically reducing the preparation time for obtaining results.
Latest Lancet Countdown report reveals climate change could increase water-borne diseases
BLOG | BluephageRising average temperatures and altered rainfall patterns are beginning to reverse...
According to the Sixth Assessment Report of the IPCC/AR 6, climate change is real and directly affects the water cycle
Bluephage is aware of the effects of climate change to ensure water quality in near real-time. For example, the consequences of floods or droughts will lead to sudden microbiological disorders in controlled human water supplies, which will require rapid and accurate microbial monitoring.
Bluephage participa en la Primera Jornada del Agua en el marco de la Feria Ecoviure de Manresa
Bluephage participa en la Primera Jornada del Agua en el marco de la Feria Ecoviure de Manresa
Bluephage wins the Innowise Scale Infrastructure Competition organized by the European Institute of Innovation and Technology, EIT
BLOG | BluephageBluephage has received the first prize of €12,000 in equity fare cash and a...
Bluephage launches a crowdfunding campaign and raises 98% of its initial goal in the first week
BLOG | Bluephage Bluephage launches a crowdfunding campaign to raise funds to launch its patented...
What can Bluephage do to combat the water scarcity crisis?
BLOG | BluephageDon't miss Bluephage's participation in the Innowise Scale competitionThis...
Global warming and human activity drastically altering surface water quality
BLOG | BluephageColiphages have been used for decades to assess surface water quality and...
To focus on water reuse as a strategy for the planet’s sustainability, guaranteeing its healthiness for human consumption
BLOG | BluephageAll water is recycled and reused as part of the hydrologic cycle.Manufactured...
Can groundwater be microbiologically contaminated?
BLOG | BluephageGroundwater from deep, confined aquifers is the water source least susceptible to...
Coliphages to ensure the absence of pathogens in biosolids
BLOG | BluephageColiphages are an excellent viral indicator in biosolids to ensure the viability...
A growing interest in coliphage surveillance in the last decade. Regulations and guidelines of the previous ten year
BLOG | BluephageColiphages are among several groups of bacteriophages that have been suggested as...
WHO publishes updated Guidelines on Recreational Water Quality, 13 July 2021
BLOG | BluephageThe Guidelines on Recreational Water Quality, which should be applied in...
How to quickly, effectively, and safely control fecal contamination in water
BLOG | BluephageWater is essential to sustain life on our planet, but it is also a matrix that...
Bluephage plays an essential role in the water consumption cycle providing quick, safe, and efficient information on viral water contamination
BLOG | BluephageThe United Nations Sustainable Development Goals pay special attention to water, a...
Meet Miriam Pascual, Chief Quality Officer (CQO) at Bluephage
BLOG | BluephageMeet the Bluephage team! Miriam Pascual is the Chief Quality Officer (CQO) at...
The European Institute of Innovation has selected Bluephage among 20 innovative companies to find solutions to water scarcity
BLOG | BluephageBluephage is presented as a proposal within the case study Public water utility...
PCR versus cultural methods to detect coliphages
BLOG | BluephageIn water analysis, microbes can be detected by culture methods or by molecular...
First regulation in a European Member State requesting to measure somatic coliphages in sludge treatment
BLOG | BluephageAn ordinance of April 20, 2021, published in the JO Legifrance of May 27,...
Why are coliphages the new viral indicators in microbiological water analysis?
BLOG | BluephageThe urgency of better water quality 1 billion people without access to safe...
Bluephage introduces its Easy Kits for Water Testing in Africa to detect pathogenic viruses
BLOG | BluephageBluephage has virtually signed a deal with a South African distributor during the...
W.A.S.H: Water, Sanitation, and Hygiene
BLOG | BluephageAccording to UNICEF, the W.A.S.H. system should be accessible to everyone,...
Why does WHO recommend testing for coliphages to ensure water quality?
BLOG | BluephageThe WHO emphasizes some microbiological aspects to ensure water qualityThe fourth...
Webinar: ¿Cómo analizar los colífagos?
BLOG | BluephageEl 16 de junio, Bluephage organizó un seminario web para profesionales de...
The new Regulation (EU) 2020/741 of the European Parliament implies the control of coliphages to validate reclaimed water for agricultural irrigation.
BLOG | BluephageAccording to these new rules, the validation control of reclaimed water for...
Is this worth concentrating virus in a water sample?
BLOG | BluephageFor human virus detection, except for wastewater samples, the concentration of...
“We help water analysts ensure the absence of disease-causing pathogenic viruses.”
Interview with Julian Martin, head of research and product development at Bluephage, and Ph.D. in Environmental Microbiology and Biotechnology (UB), with extensive experience in microbiological assessment of water quality and the use of bacteriophages as indicators of fecal contamination in the water cycle.
Are there more human viruses than coliphages?
BLOG | BluephageViruses infecting bacteria, or bacteriophages, are the most abundant biological...
Bluephage is one of the 100 first BCorp companies in Spain!
Today is a great day for Bluephage! The BCorp nameplate is already in the core of our company, the...
Bluephage simplifies and accelerates the coliphages enumeration process with all-in-one and ready-to-use solutions
Bluephage Easy Kits products for ISO or US-EPA analysis are a ready-to-use solution for standard...
Are coliphages pathogenic?
They are not. Coliphages are neither pathogenic for humans, nor animals, nor plants. They are not...
Meet the Bluephage team: Interview with Anicet R. Blanch
Why are coliphages the new viral indicators of fecal water contamination? A.R. Blanch's field of...
The urgency of investing in recreational water control to avoid waterborne disease and health care cost burden
On April 6, during the National Recreational Water Quality Workshop, organized by the US-EPA and...
Water filters and virus
What filters remove viruses from water? Learn about the most commonly used filters in the water...
Adequate access to hygiene and sanitation could significantly reduce the risk of waterborne diseases
March 22 was World Water Day, and all international organizations working to guarantee the human...
A new approach to consider the incorporation of coliphages as a viral indicator in the bathing water analysis
Next Wednesday, April 7, Anicet R. Blanch, a Microbiology professor at the University of...
Bluephage to help the water industry achieve Sustainable Development Goal 6 by 2030.
Bluephage, a biotechnology company specialized in the...
Type Solution invites Bluephage to discuss the relevance of coliphages as new viral indicators in water analysis, according to the New European Drinking Water Directive
Join the webinar "Coliphages: the new indicator of viral and fecal contamination," organized...
Bluephage is a Certified B Corporation!
Bluephage becomes the first biotechnology company specializing in microbiological water analysis...
The United Nations updates data on global progress towards ensuring water and sanitation for all by 2030
The UN-Water Integrated Monitoring Initiative has summarized data from nearly 200 countries on...
The European Parliament formally approves the new Drinking Water Directive
This new directive, which will replace the current Directive 98/83/EC, implements new operational...
Bluephage guanya el Premi Senén Vilaró a la millor empresa innovadora 2020
Bluephage ha estat escollida guanyadora del Premi Senén Vilaró a la millor empresa innovadora del...
We are honoured to have won the SME Award 2020!
Thanks to Water Europe!Watch the video (1:13) and discover more about Bluephage....